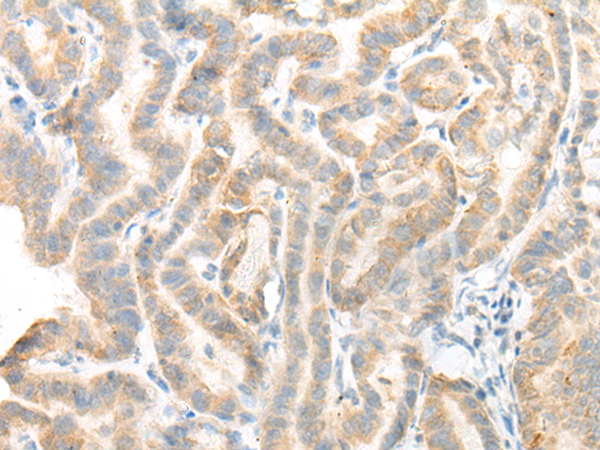
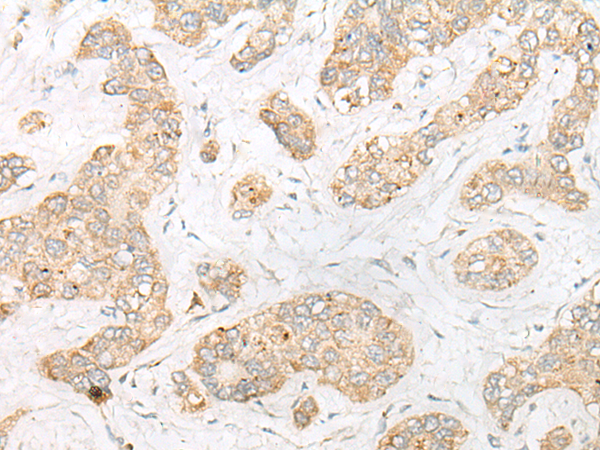
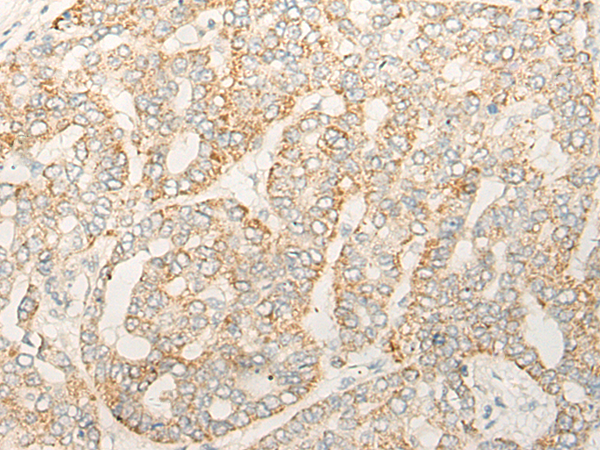

-
分类: 科研抗体货号: P13279别名: RBMS4应用: IHC反应种属: Human, Mouse
-
分类: 科研抗体货号: P13296别名: EFHA2应用: IHC反应种属: Human
-
分类: 科研抗体货号: P13276别名: PRO0327应用: IHC反应种属: Human, Mouse
-
分类: 科研抗体货号: P13294别名: MST105; ZFYVE2; MSTP105应用: WB反应种属: Human, Mouse
-
分类: 科研抗体货号: P13275别名: PEO; MDP1; SCAE; MIRAS; POLG1; POLGA; SANDO; MTDPS4A; MTDPS4B应用: IHC反应种属: Human, Mouse, Rat
-
分类: 科研抗体货号: P13293别名: CCR4; Ccr4a应用: IHC反应种属: Human, Mouse, Rat
-
分类: 科研抗体货号: P13274别名: DMGDHD; ME2GLYDH应用: IHC反应种属: Human
-
分类: 科研抗体货号: P13292别名: COE2; OE-3; EBF-2; O/E-3应用: WB反应种属: Human, Mouse
-
分类: 科研抗体货号: P13273别名: EAF2; SWC4; MEAF2; DNMAP1; DNMTAP1应用: WB,IHC反应种属: Human, Mouse
-
分类: 科研抗体货号: P13291别名: DZIP; DZIPt1应用: WB,IHC反应种属: Human

鄂公网安备42018502007531号
鄂公网安备42018502007531号

